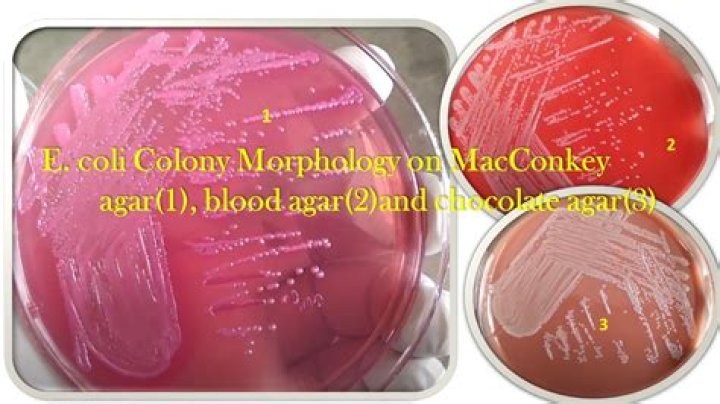
Cover

Cooking Is Key D., manager of food safety research at Consumer Reports, “but consuming any kind of raw flour can potentially lead to significant illness.” Schaffner points out that the duration and high temperature of typical baking is enough to kill E. coli or salmonella bacteria.
How long do you bake flour to kill bacteria?
Simply spread two cups of flour on a baking sheet or Silpat, and bake for about 5 minutes at 350° F. Let cool completely. Then use the flour in your preferred cookie recipe. By carrying out this toasting process, you are killing off any bacteria that might be lingering in your flour before you’ve baked the cookies.
How do you bake E. coli out of flour?
Toasting Method Some people toast raw flour in order to kill bacteria. Simply place the flour on a cookie sheet and allow it to bake for five minutes at 350 degrees. Not only will this kill bacteria, but it also creates a nutty flavor which adds a little something extra to your desired cookie recipe.
Can E. coli survive in flour?
Flour is a raw food. It may not look like a raw food, but it usually is, just like fresh tomatoes or carrots. The grains from which flour is ground are grown in fields and, like all foods grown outdoors, they may be exposed to a variety of harmful bacteria like Salmonella and pathogenic Escherichia coli (E. coli).
Can E. coli survive baking?
coli can survive the recommended cooking temperature of 160 degrees F (71 degrees C). coli survive the 160-degree F recommendation that has been the rule of thumb in Canada and the United States for years. The microbiologists studying E.
Can I microwave flour to kill bacteria?
Flour is a raw ingredient and potential carrier of foodborne pathogens. Proper cooking can eliminate potential bacteria, but there is no evidence that heat-treating flour in an oven or microwave, as many food blogs recommend, kills these pathogens.
Will baking at 350 kill bacteria?
Temperatures Necessary for Killing Bacteria Since the highest temperatures you need to kill the bacteria in eggs, casseroles and meats is 165 degrees Fahrenheit, oven temperatures of 300 F or 350 F for baking do a good job at killing both beneficial and dangerous bacteria.
How long should you heat treat flour?
Place the flour in the bowl and microwave on high for 30 seconds at a time, stirring between each interval. Stir well to make sure none of the ingredient burns (microwaves have those tricky hot spots).
What are the chances of getting E. coli from flour?
Five labs tested 32,220 batches of flour and found E. coli in one sample, for an incidence rate of 0.003 percent. Public health officials have a duty to warn people about health risks associated with specific ingredients in food.
What happens if you bake flour?
Toasting flour cooks out the raw taste so that it lends a nutty, more complex flavor to baked goods. Have you ever had fregola (small pasta balls that have been toasted), or Genmaicha tea (green tea with toasted rice)? The flavor imparted by toasted flour is similar–deeper and roasty.
How long can e coli live on flour?
Long-Term Survival of Salmonella and EHEC in Flour Long-term survival of enterohemorrhagic Escherichia coli serogroups O45, O121, O145 and Salmonella in wheat flour at room temperature (23 ± 1°C) for 24 weeks and Salmonella at 35°C (14 weeks).
Can you get food poisoning from old flour?
However, there is a small chance that eating expired flour might make you sick. “If rancid flour contains large amounts of mycotoxins, it can make you sick,” explains Knauer. Spoiled flour will smell slightly sour, but eating it typically doesn’t cause any real harm.
What flour has E coli?
Raw flour can be a dangerous ingredient when contaminated with E. coli. General Mills, Pillsbury, Aldi, and King Arthur Flour have all recalled flour due to E. coli concerns in 2019.
What food kills E. coli?
A 1 percent ratio (2 to 5 teaspoons) of garlic powder to two pounds of ground beef kills 90-97 percent of E. coli. A 3 percent ratio (2 to 5 tablespoons) of dried plum mixture (prunes) to 2 pounds of ground beef kills more than 90 percent of major food-borne pathogens, including E.
Does E. coli go away on its own?
Fortunately, most E. coli infections go away on their own. You can help yourself manage E. coli infection by drinking plenty of fluids to replace what you’ve lost through diarrhea and/or vomiting.
At what temp is E. coli killed?
160°F/70°C — Temperature needed to kill E. coli and Salmonella. While Salmonella is killed instantly at temperatures above 160F keeping the temperature for longer periods of time at lower temperatures will also be effective. See the chart below.
Can you get sick from old flour?
When flour goes rancid, its molecular structure changes — which may produce harmful compounds. However, no recent studies have revealed any detrimental effects of eating rancid flour. Although cooked foods made with it may taste unpleasant, they’re unlikely to harm your health if eaten in small amounts.
Is it better to store flour in glass or plastic?
The best way to store whole grains: airtight Or empty the flour out of its sack into a plastic bag (preferably a double bag for extra security), or a container with a tight seal: plastic or glass are equally fine. You want that flour as airtight as possible: the less air and moisture, the slower the oxidation process.
Does freezing kill E coli in flour?
Coli And Other Germs.
Do Germs burn off in the oven?
The problem isn’t with the baking process, because most viruses and bacteria are killed in a hot oven. Gerba’s work has shown that even after 72 hours, 700 viral particles of the cold virus can linger, enough to potentially sicken seven people.
Does baking kill bacteria in eggs?
Thoroughly cooking an egg kills all the harmful bacteria; “partially” cooking an egg means that some harmful bacteria can survive which can cause illness. Both undercooked egg whites and yolks have been associated with outbreaks of Salmonella Enteritidis infections.
Can bacteria survive 400 degrees?
Danger Zone! Bacteria multiply rapidly between 40 and 140 degrees. Bacteria will not multiply but may start to die between 140 and 165 degrees. Bacteria will die at temperatures above 212 degrees.